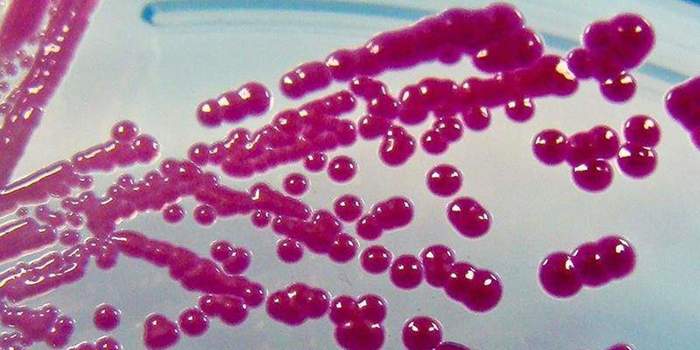

Лаборатория чумы в сша
Очередной доклад исследовательской службы Конгресса США информирует об организации системы биологической безопасности США и изменениях в ней. Тема доклада актуализирована последними событиями, связанными с эпидемией Covid-19.
В 1948 году Конгресс США запретил исследование на материковой части США опасных зоонозных заболеваний, за исключением ситуации прямого разрешения министра сельского хозяйства (21USC § 113a). В связи с этим запретом основным объектом, занимающимся исследованием опасных эпизоотий, стала лаборатория на острове Плам, штат Нью-Йорк, — недалеко от северо-восточного побережья Лонг-Айленда.
Остров Плам был приобретен правительством США еще до Первой мировой войны для строительства форта Терри, который с 1952 года был передан химическому корпусу Армии США. В ответ на эпизоотии в Мексике и Канаде в 1954 году армия передала остров Плам Министерству сельского хозяйства для создания исследовательского центра для изучения заболевания ящуром у крупного рогатого скота.
С 1954 года официальной целью работы центра была защита американского скота от болезней животных. Но в рассматриваемом докладе Конгрессу умалчивается тот факт, что PIADC в годы холодной войны занимался секретной программой биологического оружия, нацеленной на домашний скот. Исследования по биологическому оружию в PIADC не прекращались до тех пор, пока вся программа не была закрыта в 1969 году президентом Ричардом Никсоном. Но и после этого PIADC оставался секретным объектом, и впервые остров был открыт для средств массовой информации только в 1992 году.
Конкретно исследования биологического оружия в комплексе PIADC осуществлялись в здании № 257. Эксперименты на острове Плам в эпоху холодной войны по части биологической войны десятилетиями отрицались правительством США. Но в 1993 году американское издание Newsday раскопало документы, доказывающие обратное, и в 1994 году российские ученые посетили и осмотрели исследовательский центр на острове Плам, чтобы убедиться, что эти эксперименты действительно закончились. Здание № 257 было обеззаражено и закрыто в 1995 году. Сейчас оно огорожено забором из колючей проволоки и опечатано.
Помимо ящура, ученые в PIADC изучают более 40 зарубежных болезней животных, в том числе холеру свиней и африканскую чуму свиней. PIADC ежегодно проводит около 30 тыс. диагностических тестов.
В январе 2002 года издание The Wall Street Journal сообщило, что многие ученые и правительственные чиновники хотели бы закрыть лабораторию на острове Плам, полагая, что угроза ящура настолько отдаленная, что центр не заслуживал своего годового бюджета в размере $ 16,5 млн. Однако в 2002 году PIADC был переподчинен от Министерства сельского хозяйства только что созданному в 2002 году Министерству внутренней безопасности США (Департамент внутренней безопасности, DHS).
В 2002 году профсоюз работников PIADC объявил забастовку против подрядчика лаборатории, и Министерство внутренней безопасности вынуждено было привлечь нового подрядчика.
Из-за вмешательства оппозиционных законодателей в 2003 году состояние дел с объектом на острове Плам расследовало Главное управление бухгалтерского учета, которое опубликовало в октябре 2003 года отчет, в котором также критиковалось состояние с безопасностью в центре. В частности, в этом отчете утверждалось, что чиновники не контролируют доступ к опасным патогенам. В докладе также упоминались неработающие датчики дверной сигнализации, слабое наружное освещение и недостаточная проверка фона.
В феврале 2004 года сенаторы-демократы Хиллари Клинтон и Тим Бишоп выступили с совместным заявлением, в котором утверждали, что центр на острове Плам получит дополнительно $ 13 млн для модернизации и призвали должностных лиц PIADC использовать эти деньги для решения проблем, поднятых в докладе Генеральной бухгалтерии. Сенаторы также заявили, что профсоюзные работники, уволенные после забастовки, должны быть вновь приняты на работу. Исследовательские работы на острове Плам были продолжены.
Однако 11 сентября 2005 года Министерство внутренней безопасности объявило, что исследовательский центр на острове Плам будет заменен новым федеральным учреждением. Вслед за этим в 2006 году Конгресс США впервые профинансировал созданное Федеральное агентство национальной био- и агрозащитной способности (National Bio and Agro-defense Facility, NBAF), имеющее двойное подчинение — Департаменту внутренней безопасности (DHS) и Министерству сельского хозяйства США (USDA). Агентство NBAF будет работать как федеральный исследовательский центр. Официально заявленной целью NBAF стало исследование потенциально опасных зарубежных эпизоотий (FADs), которые не могут быть исследованы на существующих объектах США. По принятым планам NBAF заработает на полную возможность к декабрю 2022 года.
В настоящее время NBAF занято созданием своего центра в городе Манхэттен, Канзас, который должен превзойти Центр болезней животных на острове Плам (PIADC). Лаборатория на острове Плам работает на третьем уровне обеспечения биобезопасности (BSL-3). Это означает, что официально ей запрещено работать с патогенами, угрожающими здоровью человека.

Проект NBAF в Манхэттене, штат Канзас. Источник: perkinswill.com
BSL-4 — это самый высокий уровень биоконтроля. Лаборатории уровня BSL-4 позволяют проводить исследования экзотических возбудителей заболеваний, которые представляют высокий риск переноса их аэрозолями и вызывают смертельные заболевания, против которых нет вакцин или не существует специальных методов лечения.
По состоянию на 2017 год в США имеется восемь лабораторий уровня BSL-4, зарегистрированных в качестве федеральных, частных и академических учреждений в Соединенных Штатах.
NBAF с уровнем BSL-4 будет заниматься разработкой — от исследований до коммерческого применения — специализированных средств, например вакцин, противовирусных препаратов и тестовых наборов.
NBAF должно иметь лабораторию уровня BSL-4 для содержания крупных животных для изучения зоонозных заболеваний, требующих высокого уровня биоконтроля, таких как лихорадка Рифт-Валли или вирус Нипах. И то, и другое заболевание способно заражать людей и чрезвычайно опасно по показателю смертности. Исследование подобных заболеваний в лабораториях уровня BSL-3 запрещено.
NBAF также должно иметь лаборатории уровня BSL-3 для исследования других эпизоотий, включая, например, ящур. По данным Министерства сельского хозяйства США, вспышка ящура в США может привести к экономическим потерям от $ 15 млрд до $ 100 млрд. Как упоминалось выше, лаборатория на острове Плам PIADC является единственной в США, которой разрешено работать на живом вирусе ящура.
В 2008 году Конгресс США потребовал от главы Министерства внутренней безопасности (DHS) дать разрешение на работы с живым вирусом ящура на материковой части США на единственном объекте, который сменит PIADC — NBAF. Разумеется, существует известная озабоченность решением создать NBAF и разместить его на материковой территории США из-за потенциальной угрозы опасной утечки патогенов.

Проект NBAF в Манхэттене, штат Канзас. Источник: perkinswill.com
На острове Плам действует норма, что любое дикое млекопитающее, замеченное на острове, убивается, чтобы предотвратить возможную передачу ящура. Тем не менее объект на острове Плам допустил в 1978 году утечку ящура за пределы центра. Два эпизода подобного рода случились на острове Плам в 2004 году.
Итак, в 2006 году Министерство внутренней безопасности США объявило о своем намерении создать центр NBAF с более высоким уровнем биобезопасности в качестве новой структуры для замены устаревшего PIADC. В 2009 году Министерство внутренней безопасности выбрало город Манхэттен, штат Канзас, из пяти предложенных локаций и начало строительство центра NBAF в этом городе.
В 2017 году Министерство внутренней безопасности объявило, что после завершения строительства и ввода в эксплуатацию в мае 2021 года NBAF перейдет под управление Министерства сельского хозяйства (USDA).
В пояснительной записке для ассигнований на 2016 финансовый год указывалось, что миссией NBAF станет проведение всеобъемлющих исследований, разработка вакцин и предоставление улучшенных диагностических и тренировочных возможностей для защиты от трансграничных возникающих зоонозных заболеваний, которые угрожают продовольственным поставкам США, сельскохозяйственной экономике и здравоохранению.
В июне 2019 года Министерство внутренней безопасности и Министерство сельского хозяйства (USDA) подписали меморандум о подчиненности структур. В составе Министерства сельского хозяйства работают еще Служба сельскохозяйственных исследований (ARS) и Служба инспекции здоровья животноводства и растениеводства (APHIS). Эти службы заняты исследованиями, тестированием, разработкой диагностики и обучением персонала.
В составе Министерства внутренней безопасности работает Департамент науки и техники, который также проводит исследования и сотрудничает с Министерством сельского хозяйства в деле создания вакцин и диагностики.
Сейчас APHIS уже спонсирует программу NBAF для подготовки ученых и финансово поддерживает специализированную аспирантуру. APHIS также спонсирует программу NBAF по подготовке лаборантов на основе бакалавриата, запускаемого в Канзасском университете летом 2020 года. В создаваемом NBAF будет занято около 400 человек. Это эквивалентно текущему штату в PIADC на острове Плам.
Министерство внутренней безопасности ожидает, что NBAF начнет работать на полную мощь в 2023 финансовом году. Проектирование, строительство и ввод в эксплуатацию NBAF обойдется США в общей сложности в $ 1,25 млрд. $ 928 млн придет из федеральных ассигнований Министерства внутренней безопасности, $ 307 млн — из средств Университета Канзаса и $ 5 млн из бюджета города Манхэттен.

Проект NBAF в Манхэттене, штат Канзас. Источник: perkinswill.com
— африканская чума свиней, нет вакцин или контрмер, для человека опасности не представляет;
— классическая чума свиней, контрмеры несовершенны, для человека опасности не представляет;
— инфекционная бычья плевропневмония, контрмеры несовершенны, для человека опасности не представляет;
— ящур, необходимы вакцины против новых штаммов и более совершенные контрмеры, для человека опасности не представляет;
— вирус Хендры, необходимы вакцины и более совершенные контрмеры, передается человеку и смертельно опасен для него;
— вирус японского энцефалита, переносится комарами, необходимы вакцины и более совершенные контрмеры, передается человеку и смертельно опасен для него;
— вирус Нипах, необходимы вакцины и более совершенные контрмеры, передается человеку и смертельно опасен для него;
— лихорадка Рифт-Валли, переносится комарами, необходимы вакцины и более совершенные контрмеры, передается человеку и смертельно опасна для него.
В докладе рассматривается потенциальная угроза лаборатории NBAF в распространении экзотических заболеваний среди животных и человека. Потенциальные ответы на случайную или преднамеренную утечку возбудителей болезней из NBAF включают следующие меры: наблюдение, карантин, вакцинацию, искоренение (то есть депопуляцию или забой животных), направленный контроль (например, опрыскивание водоемов от комаров).

Официальный представитель МИД КНР Чжао Лицзянь заявил на днях, что вирус SARS-CoV-2 в китайский Ухань завезли американские военные. Дипломат пришел к такому выводу, проанализировав данные из США, в частности публикации о создании подобного вируса в научном журнале Nature Medicine за 2015 год. В нем нашлась статья, в которой ученые обсуждали, как создавали схожий с SARS-CoV-2 вирус и как он воздействует на человека.

Химера родом из США… И ее аналог в КНР?
Сразу скажем, что длительная работа ученых из разных стран мира по созданию гибридных вирусов не являлась большим секретом. Сообщения о коронавирусе летучих мышей, способном заражать человека, легко ищутся даже в обычных СМИ. Более того, проведение эксперимента, описанного в 2015 году в Nature Medicine, породило тогда целую дискуссию об этичности такого рода действий.
Конечно, цель того исследования декларировалась несколько иначе. Вирусологи из США якобы пытались доказать, что вирус SHC014, поражающий летучих мышей, уже получил необходимые белки для того, чтобы проникать в клетки человека — и только вторичные барьеры неясной природы не дают ему этого сделать. Но, как оказалось, результатом их работы стало реальное биологическое оружие, которое могло легко поражать людей.
Увы, генный код химеры SHC014-SARS в оригинальной статье Nature Medicine за 2015 год не публиковался, в том числе по этическим соображениям, поэтому мы не можем сравнить его с уже известным нам в мельчайших деталях геномом SARS-CoV-2. Однако уже понятно, что речь идет об очень похожих вирусах. Согласно исследованиям, РНК нового SARS-CoV-2 на 80% идентична оригинальному вирусу SARS 2003 года и на 96% совпала с РНК вируса SHC014, который поражает уже упомянутых азиатских подковоносых мышей.
Пока в научной среде нет согласия о пути гибридизации вируса. Обсуждается как природный вариант такого процесса, в котором промежуточными носителями называются змеи, панголины или какие-то неустановленные млекопитающие и птицы, так и вариант искусственной химеры. Так вот, именно второй вариант приводит нас на ветку конспирологических допущений.
Конечно, как и в случае с любой другой конспирологией, здесь всегда будет много альтернативных версий. Укажем лишь еще пару фактов. Во-первых, ровно такие же обвинения о рукотворном происхождении вируса прозвучали и в Сенате США — только на этот раз мишенью обвинений ожидаемо стал сам Китай. Во-вторых, с коронавирусами летучих мышей столь же активно, как и в США, экспериментировали в китайской Ухани, где, кстати, располагалась крупнейшая биолаборатория КНР по изучению подобных вещей.

Следующие новости о неких связанных событиях приходят к нам уже из не столь далекого 2019 года. Напомним, к тому времени в США резко поменялась политика в отношении Китая: вместо весьма мягкой позиции предыдущего президента Барака Обамы появилась доктрина Трампа, которая к началу прошлого года привела к постепенному обострению торговой войны. Но это, так сказать, фон.
Дональд Трамп, с подачи Центров по контролю и профилактике инфекций (Centers for Disease Control and Prevention, CDC), созывает рабочее совещание на тему. ограничения продажи вейпов и электронных сигарет. В ответ на это NYT отмечало, что такая постановка проблемы никак не согласуется с картиной заболевания — болеют даже те, кто вообще ничего не курил.
Тем не менее, некоторые пораженные неизвестной инфекцией штаты принялись вводить или рассматривать возможность введения запрета на продажу электронных сигарет и вейпов. Благо теперь можно было свалить все не только на классических курильщиков, но и на их модных последователей.

Интересно, что парадоксальные действия администрации Трампа плохо согласуются с еще одной утечкой. Как сообщило американское издание Politico, администрация Белого дома еще в начале 2017 года отрабатывала алгоритм действий на случай пандемии болезни типа птичьего гриппа.
По информации журналистов, незадолго до инаугурации Трампа администрация уходящего президента Обамы проводила специальный брифинг для команды следующего хозяина Овального кабинета. Целью брифинга являлась отработка основных сценариев возможных чрезвычайных ситуаций, с которыми США могут столкнуться в будущем.
Дальше события пошли еще интереснее. Все в той же Ухани месяц спустя, 18–27 октября 2019 года, проходили World Military Games — международные спортивные соревнования военнослужащих. Американская делегация насчитывала 172 участника — это была четвертая по размеру команда после немецкой, польской и китайской.

Вирус создан в американских пробирках?
Итак, альтернативная версия пандемии COVID-19 выглядит следующим образом.
Кстати, в версию сокрытия правды о происхождении вируса укладывается и бездействие CDC и администрации Трампа: признание утечки из военной биолаборатории стало бы крахом политической и государственной карьеры для слишком широкого круга лиц, в силу чего происхождение эпидемии, вероятно, было решено скрывать до последнего.

Впрочем, не будем сбрасывать со счетов и ту конспирологическую теорию, по которой SARS-CoV-2 был рукотворно выведен в лаборатории китайской Ухани, где в течение четырех лет до этого могли идти аналогичные эксперименты с вирусом азиатских подковоносых мышей.
Российский государственный научно-исследовательский центр вирусологии в сибирском городе Кольцово располагает одной из крупнейших коллекций опасных вирусов в мире. Во время холодной войны сотрудники лаборатории занимались разработкой биологического оружия и средств защиты от него, и, как сообщается, в лаборатории среди прочих вирусов хранились опасные штаммы черной оспы, споры сибирской язвы и вирус, вызывающий лихорадку Эбола.
Так что прозвучавший в понедельник взрыв серьезно встревожил многих.
По данным российских независимых СМИ, взорвался газовый баллон, когда в лаборатории шел ремонт. В результате вспыхнувшего пожара площадью 30 квадратных метров от ожогов серьезно пострадал один из сотрудников. По сообщениям, взрывной волной были разбиты стекла по всему зданию, а огонь стремительно распространился по вентиляционной системе.
В мире остались только две лаборатории, где до сих пор хранятся образцы черной оспы: это российская лаборатория Кольцово и еще одна — в Соединенных Штатах. Последний случай заражения черной оспой в естественных условиях был зарегистрирован в 1977 году.
Так-то оно так, но для хранения смертельных патогенных микроорганизмов, вроде оспы, уставлен очень строгий порядок. Мэр города заявил, что случившееся не представляет никакой угрозы для населения, а представитель центра заверил, что в кабинете, где произошел взрыв, не было никаких опасных патогенных микроорганизмов. (Разумеется, официальные сообщения российских властей об опасных инцидентах не всегда в точности соответствуют действительности.)
Смогут ли опасные болезни покинуть лабораторию и заразить население? Почти наверняка — нет; подавляющее большинство несчастных случаев в лабораториях, даже очень серьезных, не становятся причиной болезней, и еще ни один из них не вызывал пандемию среди людей.
Но это не означает, что мы не должны быть все время начеку. Сами по себе взрывы относительно редки, между тем катастрофические аварии с выбросом опасных патогенов на удивление крайне распространенное явление — и не только в России, но и в Соединенных Штатах и Европе. Начиная со случайного заражения оспой и сибирской язвой и заканчивая ошибочным переносом смертоносных штаммов гриппа — подобные оплошности в работе с рядом наиболее опасных веществ в мире происходят сотни раз в год.
Что с этим делать? Разумеется, сворачивать исследования в области вирусологии и патогенов — исследования, которые спасли бесчисленное количество жизней — не стоит. Так, именно благодаря изучению вируса Эбола исследователи смогли разработать нынешний набор методов лечения, которые способны сделать эту болезнь, некогда считавшуюся смертным приговором, вполне легкой и излечимой.
Смертельные случаи
В 1977 году в природе был диагностирован последний случай заболевания черной оспой. Это был финальный аккорд многолетней кампании по искоренению оспы — смертельной инфекционной болезни, которая убивает примерно 30 процентов тех, кто ею заразился. На протяжении столетия, предшествовавшего ее уничтожению, от оспы умерло около 500 миллионов человек.

Однако в 1978 году произошла новая вспышка болезни — в Бирмингеме (Великобритания). Джанет Паркер (Janet Parker) работала фотографом в медицинской школе Бирмингема. Когда у женщины появилась ужасающая сыпь, врачи поначалу диагностировали ей ветряную оспу. Но Паркер стало хуже, и ее отправили в больницу, где анализы показали черную оспу. Женщина скончалась через несколько недель.
Как же она заразилась болезнью, которая, как считалось, полностью побеждена?
Может ли что-то подобное случиться сегодня?
В 2004 году в той же российской вирусологической лаборатории, которая на днях пострадала от взрыва, произошел еще один инцидент: один из ученых умер после случайного заражения лихорадкой Эбола. Россия признала этот факт лишь несколько недель спустя.
Исследования вирусов помогают разрабатывать лекарства и понять, как прогрессирует заболевание. Мы не можем обойтись без этих исследований. К тому же есть много мер предосторожности, которые гарантируют, что то или иное исследование не угрожает людям. Но, как показывает долгая череда инцидентов, начиная с 1978 года вплоть до взрыва, произошедшего в понедельник в России, порою эти меры предосторожности не срабатывают.
Как патогены могут оказаться за пределами лаборатории
Изучение патогенов и токсинов позволяет разрабатывать вакцины, диагностические тесты и методы лечения. Новые биологические методы также позволяют проводить более спорные формы исследований, в том числе делать болезни более заразными или смертоносными — чтобы предсказать то, как они могут мутировать в естественных условиях.
Таким образом, это исследование действительно может играть важную роль и быть ключевым фактором в общих усилиях по защите здоровья общества. К сожалению, учреждения, выполняющие такого рода работу, не избавлены от серьезного риска: человеческой ошибки.
Смерть от оспы в 1978 году, как показало большинство анализов, стала результатом небрежности — недобросовестного соблюдения техники безопасности в лаборатории и плохо спроектированной вентиляции. Большинство людей хотели бы думать, что сегодня такая халатность не допустима. Однако нельзя сказать, что страшные аварии — вызванные человеческими ошибками, сбоями в программном обеспечении, плохим обслуживанием оборудования и сочетаниями всех вышеперечисленных факторов — полностью остались в прошлом, доказательством тому служит инцидент в России.
В 2014 году, когда Управление по надзору за качеством пищевых продуктов и медикаментов (FDA) проводило уборку для запланированного переезда в новый офис, сотни бесхозных пузырьков с образцами вируса были обнаружены в картонной коробке в углу холодильной камеры. Шесть из них, как оказалось, были пузырьками с оспой. Никто их не проверял; никто не знал, что они там находились. Они могли храниться там с 1960-х годов.
В панике ученые сложили материалы в коробку, запечатали их прозрачной упаковочной лентой и отнесли в кабинет руководителя. (По технике безопасности так нельзя обращаться с опасными биологическими материалами.) Позднее обнаружилось, что целостность одного из флаконов была нарушена — к счастью, в нем не содержался смертельный вирус.
Инциденты 1978 и 2014 годов, равно как и катастрофа в России, привлекли к себе особое внимание потому, что были связаны с черной оспой, однако случаи непреднамеренной утечки контролируемых биологических агентов на самом деле довольно часты. Каждый год имеют место сотни подобных инцидентов, хотя не все из них связаны с потенциально пандемическими патогенами.
В 2014 году исследователь случайно заразил довольно безвредный птичий грипп гораздо более опасным штаммом, который был помещен с ним в одну пробирку. Затем смертельно опасный птичий грипп через всю страну переправили в лабораторию, у которой не было разрешения на обработку такого опасного вируса: там он использовался для исследования кур.
Отметим, что подавляющее большинство этих ошибок никогда не приводит к заражению людей. И хотя число 1059 не может не впечатлять, на самом деле речь идет о довольно низком уровне несчастных случаев — работа в лаборатории с контролируемыми биологическими агентами считается довольно безопасной по сравнению со многими профессиями, такими как перевозчик грузов или рыбак.
Правда, автомобильная авария или инцидент на море в худшем случае убьет несколько десятков человек, в то время как жертвами инцидента с пандемическим патогеном потенциально могут быть несколько миллионов. Принимая во внимание высокие ставки и наихудшие сценарии, сложно — при взгляде на эти цифры — заключить, что наши меры предосторожности против катастрофических бедствий достаточны.
Сложности в безопасном обращении с патогенами
Почему в ходе лабораторных исследований так сложно избегать подобного рода ошибок?
Имеющийся у CDC перечень сообщений о сбоях в соблюдении мер предосторожности помогает ответить на этот вопрос. Ошибки приходят по самым разным причинам. С тревожной частотой люди совершают манипуляции с живыми вирусами, полагая, что им дали вирусы деактивированные.
Эти проблемы возникают не только в США. Недавнее расследование, проведенное в Великобритании, показало следующее:
в период с июня 2015 года по июль 2017 года в специализированных лабораториях произошло более 40 несчастных случаев, то есть с частотностью один раз в две-три недели. Помимо нарушений, которые вызвали распространение инфекций, были совершены и грубые ошибки — например, использование вируса денге, который ежегодно уносит жизни 20 тысяч человек во всем мире; кроме того, персонал, работавший с потенциально смертельными бактериями и грибами, не предпринимал соответствующих мер безопасности; и был зарегистрирован один случай, когда студенты в Университете Западной Англии, сами того не зная, изучали живые микробы, вызывающие менингит, которые, по их мнению, должны были погибнуть в результате термической обработки.
Легко понять, почему эти проблемы трудно решить. Введение дополнительных правил для тех, кто занимается патогенными микроорганизмами, не поможет, если обычно заразу подхватывают те, кто с патогенными микроорганизмами не работает. Введение новых правил на федеральном и международном уровнях не поможет, если эти правила не будут последовательно соблюдаться. И если в стандартах по сдерживанию по-прежнему имеются неопознанные технические недостатки, как мы узнаем о них до тех пор, пока их не выявит тот или иной инцидент?

Именно эти тревожные размышления в последнее время снова звучат в новостях, поскольку правительство США одобрило исследование, направленное на то, чтобы сделать некоторые смертоносные вирусы гриппа более вирулентными, то есть облегчить их распространение от человека к человеку. Вовлеченные исследователи хотят подробнее изучить явления трансмиссивности и вирулентности, чтобы лучше подготовить нас к борьбе с этими болезнями. Лаборатории, проводящие такие исследования, предприняли необычные шаги для обеспечения их безопасности и снижения риска вспышки.
Липсич не считает, что мы должны ужесточать стандарты для большинства исследований. Он утверждает, что наш нынешний подход, хотя показатель его ошибок никогда не будет равен нулю, является неплохим балансом научных и глобальных усилий в области здравоохранения и безопасности — это справедливо для большинства биологических исследований патогенов. Но, отмечает он, в отношении наиболее опасных патогенов, которые могут вызвать глобальную эпидемию, этот расчет не действует.
До сих пор политика биобезопасности слишком часто носила реактивный характер: ужесточение стандартов предпринималось после того, как что-то шло не так. Учитывая потенциальные сценарии бедствий, этого явно недостаточно. Сделать наши лаборатории более безопасными чрезвычайно сложно, но, когда дело доходит до самых опасных патогенных микроорганизмов, мы просто обязаны принять этот вызов.
Материалы ИноСМИ содержат оценки исключительно зарубежных СМИ и не отражают позицию редакции ИноСМИ.

Место проведения: Сан-Франциско, США
Время проведения: с 20 по 27 сентября 1950 г.
Президент: Гарри Трумэн
В течение семи дней ВМС США из огромных брандспойтов, расположенных на минном тральщике, распылили значительное количество бактерий Serratia Marcescens и Bacillus Globigii, образовавших целое облако, которое зависло над 800 тысячами жителями залива. Место проведения операции было выбрано ввиду его близости к морю, высокой плотности населения, наличию небоскребов, а также потому, что большая облачность в этой местности помогала скрыть массу патогенных веществ и способствовала ее распространению на близлежащие города.
Цель учения: изучить воздействие этого оружия НЕ на здоровье людей, а на:
— Потоки ветра, разносившие смертоносные бактерии.
— Дымку, которая перемещала бы бактерии на огромные расстояния.
— Время, за которое бактерии достигнут других областей, и количество бактерий, необходимое для их заражения.
— Исследовать уязвимость большого города в результате применения биологического оружия, его воздействие на окружающую среду и способы борьбы с ним.
Serratia Marcescens была выбрана по двум причинам:
1.Эта бактерия не столь смертоносна как сибирская язва (Bacillus Anthracis), та самая, которую в 2003 году Саддам Хусейн не рассылал в почтовых конвертах в США (это был один из предлогов для вторжения в Ирак). Этим занимался агент ФБР Брюс Ивинс, в течение 18 лет работавший в Военном институте изучения инфекционных заболеваний и разрабатывавший вакцину против этой бактерии: он заразил 22 своих соотечественников, пятеро из которых погибли.
В тот же год похожие эксперименты были проведены в округах Кэлхун (Алабама) и Кей-Вест (Флорида), спровоцировав всплеск пневмонии.
Итог: это был самый настоящий успех для криминального военно-промышленного комплекса и его политических представителей, став крупнейшим в истории экспериментом с биологическим оружием. Образцы, взятые в 43 областях распространения бактерий, показали их эффективность: помимо залива, патогенными веществами оказались заражены близлежащие города. Их жители узнают об этом гораздо позже, благодаря журналистскому расследованию, проведенному газетой Лонгдэй Ньюсдей (Longday Newsday) в 1976 году.

Данные из американской прессы:
1920: Проводя эксперименты с людьми, военные распылили Serratia Marcescens над группой американских военнослужащих, чтобы оценить их действие. Вскоре они узнают, что данные бактерии вызывают сепсис, респираторные заболевания, эндокардит, остеомиелит, глазные инфекции и менингит.
1942: Американская программа разработки биологического оружия приобретает государственный характер в соответствии с указом президента Ф. Рузвельта.
1947: Нюрнбергский кодекс, разработанный на основе разоблачений экспериментов над людьми, проводившимися в немецких и японских концлагерях, устанавливал этические нормы для подобных исследований, в частности: 1) они могли проводиться только при согласии добровольцев, которые 2) должны были быть должным образом проинформированы относительно характера экспериментов и их последствий. Лишь четыре года спустя США нарушат этот Кодекс, осуществив в Сан-Франциско один из крупнейших в истории экспериментов над людьми.
1948: США создают Комитет по бактериологической войне и разрабатывают программу экспериментов над населением. В тот же год Пентагон открывает Центр биологической войны на острове Сан-Хосе в Панаме, где устраивает склад отравляющих веществ, иприта и веществ нервно-паралитического действия.
1951: Военные вводят чернокожим работникам Центра промышленных поставок в Норфолке грибок Aspergillus fumigatus, вызывающий легочные заболевания и астму у людей с ослабленным иммунитетом, чтобы определить степень восприимчивости афроамериканцев к данной инфекции.
Май 1965: Военные распыляют бактерии Bacillus Globigii в аэропорту Вашингтона и на автобусной остановке Грехаунд Лайнс. Десятки пассажиров увезли их на себе в 35 городов семи штатов.
1994: Доклад сенатора Джона Рокфеллера показывает, что в течение десятилетий американские военные преднамеренно подвергали сотни тысяч своих собственных солдат воздействию опасных микробов, иприта, нервно-паралитического газа, радиации, галлюциногенных и психотропных веществ.
Но разве задачей армии, спецслужб и наших руководителей не является защита граждан от врагов, как нас убеждают?
Материалы ИноСМИ содержат оценки исключительно зарубежных СМИ и не отражают позицию редакции ИноСМИ.
Как заразить Сан-Франциско: незаметно и безнаказанно
Американская военщина распыляет микробы по американскому же городу… 70 лет назад это было не фантастикой и не бредом, а просто скучной реальностью. Осенью 1950 года американский тральщик бороздил воды бухты Сан-Франциско. Но бороздил не просто так, а с абсолютно секретной миссией. Он распылял в воздухе бактерии. Зачем?
Красное и чёрное
После Второй мировой войны в Штатах задумались — а что, если какие-нибудь враги применят бактериологическое оружие? По первым прикидкам, население и Армия США могли даже не заметить, что их атаковали, — пока не будет слишком поздно. Причём, в отличие от дорогой и сложной атомной бомбы, бактериологическое оружие могли уже тогда разрабатывать многие страны.
Найти какой-нибудь имитатор боевых бактерий. Возьмём бациллу Серрация марцесценс (Serratia marcescens). Эта бактерия спокойно живёт в почве и воде. И, что полезнее всего, — вырабатывает ярко-красный пигмент. То есть эти бактерии легко отслеживать. Кроме того, она непатогенна — не наносит вреда человеку. Другая бактерия, Bacillus globigii, окрашивает заражённые области в чёрное. Тоже легко заметно.
Serratia marcescens. Милая, правда?
Для имитации атаки выбрали небольшой корабль. С него шесть дней, с 20 по 27 сентября, шлангами распыляли аэрозоли с выбранными двумя бактериями — каждый день по полчаса. Четыре дня — Bacillus globigii, и два дня — Serratia marcescens. Тральщик шёл параллельно берегу, проделывая за время выброса путь от двух до четырёх миль.
При каждом испытании тщательно замеряли температуру и влажность воздуха, курс и скорость судна, направление и скорость ветра. Позже в сорока трёх местах делали замеры количества бактерий.
Испытания прошли успешно — по подсчётам военных, почти каждый из 800 тысяч жителей Сан-Франциско надышался бактериями.
Военные сделали выводы. Во-первых, атака приморского города бактериологическим оружием с судна вполне возможна. Во-вторых, успех атаки будет зависеть от метеорологических условий в момент её проведения. В-третьих, тесты дали Армии США полезную информацию о распространении бактерий.
Через четыре дня после первого выброса в госпитале университета Стенфорда впервые диагностировали болезнь, вызванную Serratia marcescens. За следующие пять месяцев нашли ещё десять человек с той же инфекцией. Причём один — Эдвард Невин — даже умер.
Доктора госпиталя честно написали о любопытном случае в научный журнал Arhives of Internal Medicine: так, мол, и так — эта бактерия считалась непатогенной, но есть нюансы.
А в 1976 году разразился скандал. Эдвард Невин-третий, внук покойного, прочитал свежую статью об испытаниях, где нашёл фамилию деда. Невин-младший поднял бучу. Начались слушания в Сенате США и разбирательства в суде.

Генерал Уильям Кризи, глава химической и бактериологической службы Армии США
Военные частично открыли архивы. Десятки раз в США распыляли в воздухе разнообразные микробы, думая, что они безвредны. От Сан-Франциско в Калифорнии до Ки-Уэста во Флориде. И даже в метро Нью‑Йорка.
Выяснилось, что бактерия Serratia marcescens безвредна — но только при строго определённых условиях. Тысяча и даже десять тысяч бактерий не приведут к болезни здорового человека. А вот бо́льшие количества — могут. Особенно если несчастный человек и без того был не очень здоров.
Эдварду Невину было 75 лет — он лежал в госпитале, леча простату. Чувствовал себя хорошо и уже шёл на поправку. Но 29 сентября 1950 года, спустя два дня после завершения испытаний, Невину стало гораздо хуже. В середине октября он умер.

Почему США вообще проводили такие опыты? Потому что бактериологическая война выглядела крайне перспективной штукой. В 1969 году на слушаниях в ООН эксперты сообщили, что против мирного населения в расчёте на квадратный километр потребуется: 2000 тогдашних долларов для обычного оружия, 800 долларов — для ядерного, 600 — для нервно-паралитических газов, и всего один доллар в случае применения бактериологического оружия.
Достоверность этих выводов в реальной войне, конечно, никто не проверял — но идеи нравились.
Тем временем заседания всё продолжались. Наконец в 1981 году суд решил, что Армия США не виновата. Точка.
Общественность, конечно, возмутилась — но что поделать? С Армией США не шутят.
![]()
А, сторонник теории заговора - ты

![]()
Военный интерес: ВВС США хотят закупить образцы живых тканей россиян
Новость немного от Слоупока, но всё же.
Среди условий контракта есть указания на то, что доноры синовиальной оболочки не должны иметь травм опорно-двигательного аппарата и болеть ВИЧ, гепатитом B, C или сифилисом. Отмечается, что образцы оболочки и РНК могут поступать от разных доноров. При их предоставлении необходимо указать пол, возраст, этническую принадлежность, стаж курения, медицинскую историю, рост, вес и другие данные. Жители Украины не допускаются к контракту.

Перевод вопросов c сайта:
Q1: Для образцов РНК: какое минимальное количество?
А1: смотрите Приложение № 2 "График поставки" к оригиналу обращения. Правительству требуется 12 образцов каждой нормальной рибонуклеиновой кислоты человека (РНК).
Q2: Вы рассматриваете образцы от Украины?
A2: Нет, все образцы (образцы синовиальной ткани и РНК) должны быть собраны из России и могут быть кавказскими. Правительство не будет рассматривать образцы тканей из Украины.
Q3: Вы признавали бы перспективную коллекцию или только образцы от ретроспективных коллекций?
A3: Правительство принимает ретроспективные коллекции.
Все остальные условия тендера остаются без изменений.
Тендером заинтересовалась американская медицинская клиника ProteoGenex, которая находится в городе Калвер-Сити (Калифорния). На сайте организации говорится, что она специализируется на сборе человеческих тканей, в том числе РНК, которая извлекается из крови донора. Также отмечается, что в распоряжении ProteoGenex имеются 200 тыс. различных образцов биоматериала.
Головной офис компании ProteoGenex в Калифорнии не ответил на вопрос RT относительно участия в тендере на предоставление образцов живых тканей россиян Военно-воздушным силам США.
На протяжении многих лет генетики изучали распространённые варианты последовательности ДНК человека, ассоциированные с развитием комплексных заболеваний, таких как сахарный диабет и сердечно-сосудистые заболевания. Данный подход позволил получить важные сведения, но выявленные распространенные варианты часто вносят лишь небольшой генетический вклад в развитие заболеваний у отдельных людей.
В настоящее время исследователи всё больше внимания уделяют вкладу редких генетических вариантов в развитие заболеваний. Комбинации этих вариантов могут содержать ключ к уникальным характеристикам человека. Поскольку до недавнего времени население России было географически изолировано, оно обладает уникальными генетическими характеристиками. В результате распространенность некоторых вариантов, которые очень редко встречаются в других популяциях, может быть выше в России, что облегчает их выявление и исследование. Поэтому, конечно же прав военный эксперт и бывший член комиссии по биологическому оружию ООН Игорь Никулин, заявляя, что образцы РНК могут использоваться для разработки вирусов.
Однако, здесь очевидно одно, главная цель, которая доминирует в сознании западной правящей клики, — было сокращение численности населения в богатых ресурсами странах. Но вопрос заключался в том, как спроектировать массовую отбраковку населения по всему миру без ущерба возникновения мощной протестной реакции, поскольку, если эти планы станут известны широкому кругу населения, то это должно произойти.
Когда запасы нефти в США достигли пика в 1972 году, и они стали нетто-импортёром нефти, ситуация стала тревожной, и повестка дня заняла центральное место. Киссинджер, один из ключевых стратегов Никсона, воспитанный Рокфеллерами, подготовил так называемую записку по изучению национальной безопасности (NSSM # 200), в которой он разработал свой план сокращения численности населения. В этой записке он специально ориентировался на тринадцать стран: Бангладеш, Бразилию, Колумбию, Египет, Эфиопию, Индию, Индонезию, Нигерию, Пакистан, Турцию, Таиланд и Филиппины. Теперь, по мере продвижения этого плана, в список попали Украина, Россия и Белоруссия.
Военный эксперт и бывший член комиссии по биологическому оружию ООН Игорь Никулин отметил, что образцы РНК могут использоваться для разработки вирусов.
Читайте также:


